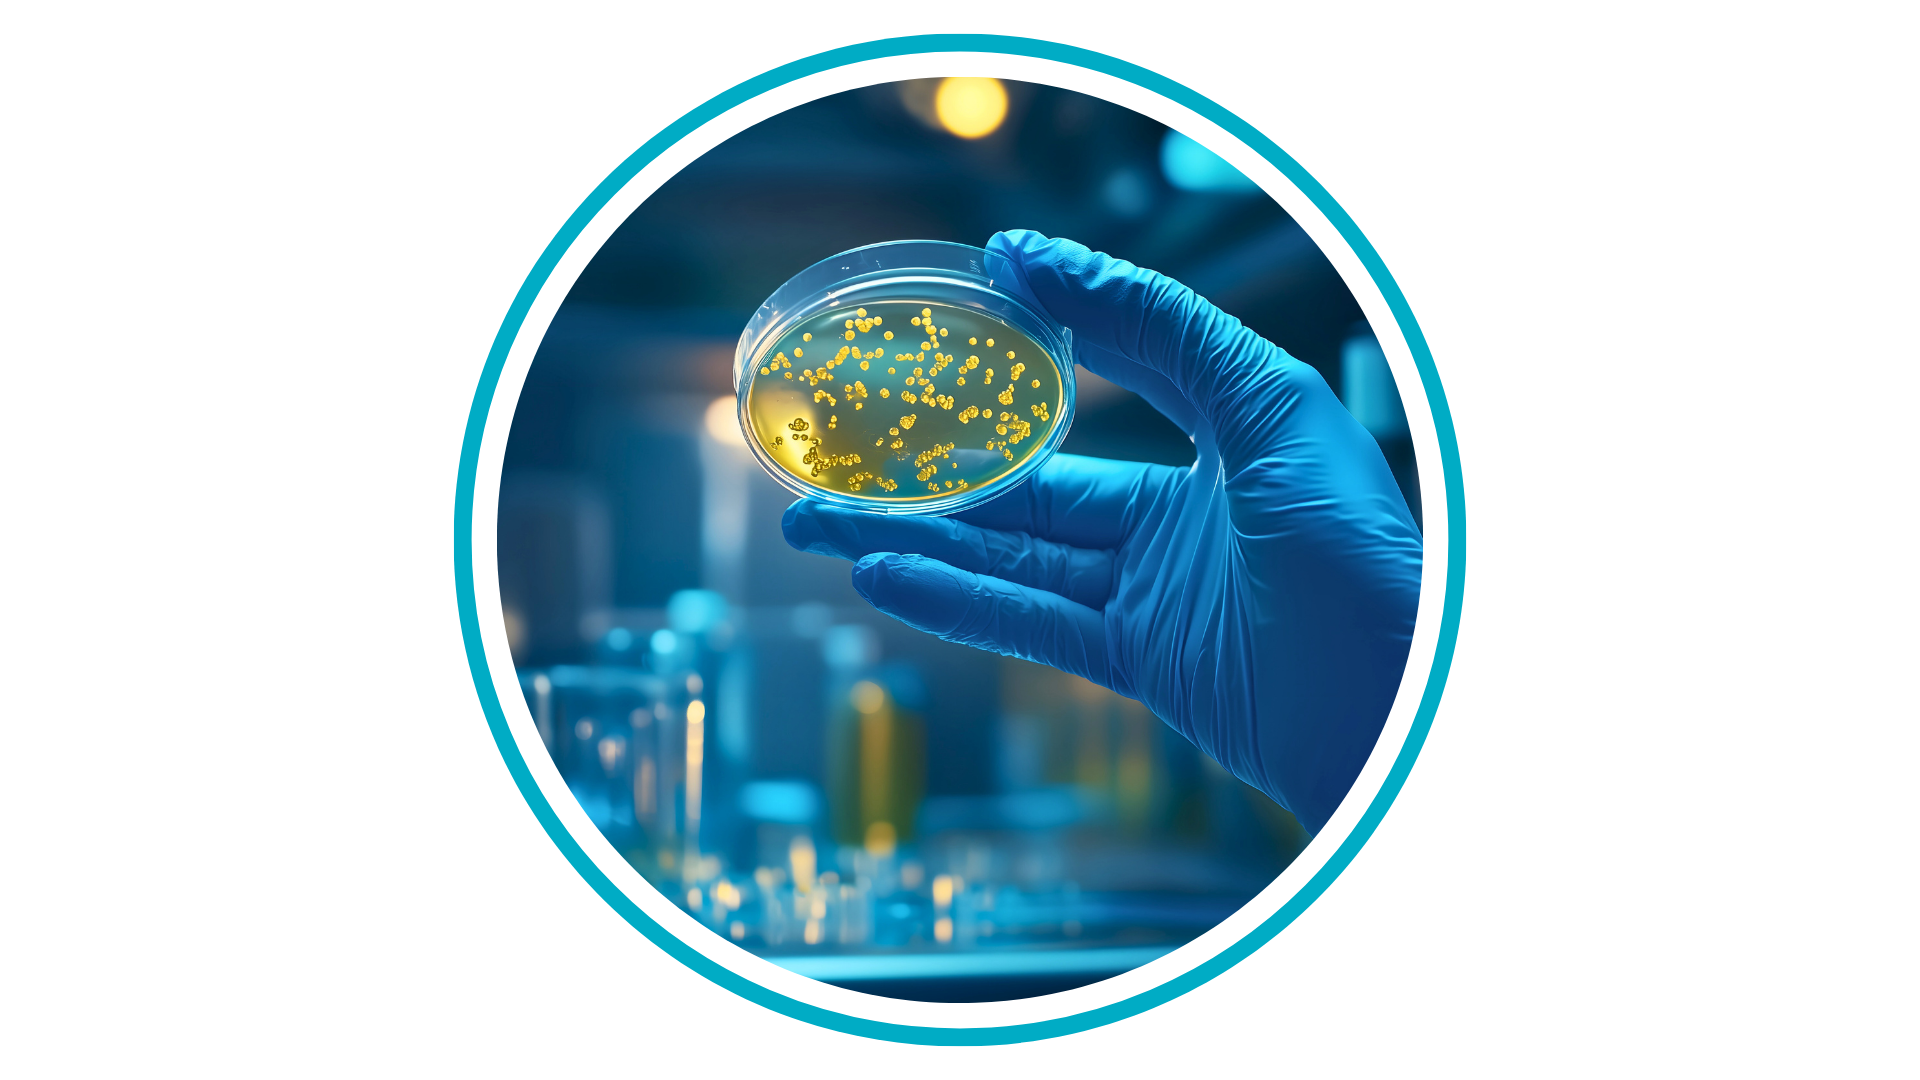
microbiology, representing Biobridge's important work in san antonio

QualTex Laboratories offers comprehensive microbiology testing and specialized assays to support product safety and compliance across the biopharmaceutical, tissue, and cleanroom manufacturing industries. Fast turnaround times and reliable, high‑quality results are achieved through state‑of‑the‑art automation and advanced technical expertise.
Beyond routine and specialized testing, QualTex Laboratories offers custom assay development and R&D capabilities, delivering flexible solutions tailored to unique client needs.
QualTex’s Microbiology Laboratory is FDA registered and holds ISO, TGA, and CLIA certifications.